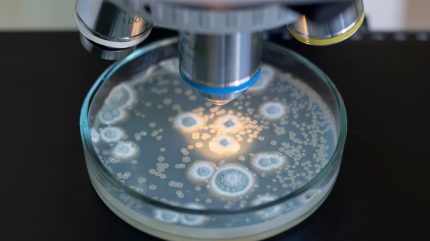

The World Health Organization (WHO) has outlined desired antibacterial characteristics for three priority infections as part of a move to direct research towards developing urgently needed antibiotics.
The three Target Product Profiles (TPPs) published by WHO include specific guidance on the development of new treatments, providing a developmental framework to align innovation. The new TPPs are in line with the agency’s bacterial priority pathogen list, aiming to foster collaboration between public and private sector partners to incentivise and reduce the risks associated with research and development for infections with significant healthcare burden.

Discover B2B Marketing That Performs
Combine business intelligence and editorial excellence to reach engaged professionals across 36 leading media platforms.
Severe multidrug-resistant (MDR) gram-negative infections, severe gram-positive infections in immunosuppressed and critically ill patients, and bacterial meningitis have been picked by WHO as three global priorities for innovation. Developing better antibiotics for these would help address severe bloodstream and urinary tract infections, pneumonia and central nervous system inflammations in at-risk populations worldwide. Bacterial meningitis remains particularly dangerous – of those affected, approximately one person in six dies.
Despite 90 new antibacterial agents being in preclinical or clinical development across various infections, as per the WHO’s antibacterial 2025 report, few clinical candidates target bacterial priority pathogens. The agency considers even a smaller amount as ‘innovative’.
Dr Yvan Hutin, director of antimicrobial resistance at WHO, said: “The scientific community has developed and approved new antibiotics in recent years. This is good, but unfortunately not sufficient to catch up with evolving drug-resistance bacteria, especially against those of greatest concern.
“We need a reliable pipeline with new antibacterial agents that are innovative, affordable and accessible to all those who need them.”
AMR’s health burden
Antimicrobial Resistance (AMR) occurs when bacteria, viruses, fungi, and parasites evolve to withstand antimicrobial medicines. In the case of resistant bacteria, antibiotics can be rendered ineffective. In 2023, approximately one in six laboratory-confirmed bacterial infections worldwide were caused by bacteria resistant to antibiotics. It is estimated that bacterial antimicrobial resistance (AMR) was directly responsible for 1.27 million global deaths in 2019, the last year data of this kind is available. It is forecast that AMR will cause ten million deaths by 2050 unless action, such as developing more advanced antibiotics, is taken.
In October 2025, the WHO asked its member states, donors and partners to strengthen a coordinated response against AMR. At the time, the health authority was asking for $85m every two years to help fight the public health issue. It is unclear how the US’s departure from WHO will affect AMR specifically, but experts generally believe that global health efforts at the agency will be hampered. The US has historically been the WHO’s largest donor.
Other regions have established their own campaigns. The UK, for example, pledged £210m ($267.7m) to help track antibiotic-resistant bacteria across Asia and Africa. The investment, which supports The Fleming Fund’s global antimicrobial resistance surveillance (AMR) programme, aims to identify dangerous superbugs before they arrive in the UK. In September 2025, the European Union launched a €253m initiative to combat AMR.




